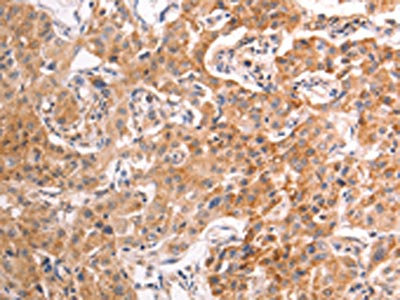

TRPV4 Antibody
-
中文名稱:TRPV4兔多克隆抗體
-
貨號:CSB-PA024643
-
規(guī)格:¥1100
-
圖片:
-
The image on the left is immunohistochemistry of paraffin-embedded Human thyroid cancer tissue using CSB-PA024643(TRPV4 Antibody) at dilution 1/40, on the right is treated with fusion protein. (Original magnification: ×200)
-
The image on the left is immunohistochemistry of paraffin-embedded Human liver cancer tissue using CSB-PA024643(TRPV4 Antibody) at dilution 1/40, on the right is treated with fusion protein. (Original magnification: ×200)
-
-
其他:
產(chǎn)品詳情
-
Uniprot No.:
-
基因名:
-
別名:BCYM3 antibody; CMT2C antibody; HMSN2C antibody; osm 9 like TRP channel 4 antibody; Osm-9-like TRP channel 4 antibody; OSM9 like transient receptor potential channel 4 antibody; Osmosensitive transient receptor potential channel 4 antibody; OTRPC 4 antibody; OTRPC4 antibody; SMAL antibody; SPSMA antibody; SSQTL1 antibody; Transient receptor potential cation channel subfamily V member 4 antibody; Transient receptor potential protein 12 antibody; TRP 12 antibody; TRP12 antibody; TRPV 4 antibody; TrpV4 antibody; TRPV4_HUMAN antibody; Vanilloid receptor like channel 2 antibody; Vanilloid receptor like protein 2 antibody; Vanilloid receptor related osmotically activated channel antibody; Vanilloid receptor-like channel 2 antibody; Vanilloid receptor-like protein 2 antibody; Vanilloid receptor-related osmotically-activated channel antibody; VR 4 antibody; VR OAC antibody; VR-OAC antibody; VR4 antibody; VRL 2 antibody; VRL-2 antibody; VRL2 antibody; VROAC antibody
-
宿主:Rabbit
-
反應(yīng)種屬:Human,Mouse,Rat
-
免疫原:Fusion protein of Human TRPV4
-
免疫原種屬:Homo sapiens (Human)
-
標記方式:Non-conjugated
-
抗體亞型:IgG
-
純化方式:Antigen affinity purification
-
濃度:It differs from different batches. Please contact us to confirm it.
-
保存緩沖液:-20°C, pH7.4 PBS, 0.05% NaN3, 40% Glycerol
-
產(chǎn)品提供形式:Liquid
-
應(yīng)用范圍:ELISA,IHC
-
推薦稀釋比:
Application Recommended Dilution ELISA 1:2000-1:10000 IHC 1:50-1:200 -
Protocols:
-
儲存條件:Upon receipt, store at -20°C or -80°C. Avoid repeated freeze.
-
貨期:Basically, we can dispatch the products out in 1-3 working days after receiving your orders. Delivery time maybe differs from different purchasing way or location, please kindly consult your local distributors for specific delivery time.
-
用途:For Research Use Only. Not for use in diagnostic or therapeutic procedures.
相關(guān)產(chǎn)品
靶點詳情
-
功能:Non-selective calcium permeant cation channel involved in osmotic sensitivity and mechanosensitivity. Activation by exposure to hypotonicity within the physiological range exhibits an outward rectification. Also activated by heat, low pH, citrate and phorbol esters. Increase of intracellular Ca(2+) potentiates currents. Channel activity seems to be regulated by a calmodulin-dependent mechanism with a negative feedback mechanism. Promotes cell-cell junction formation in skin keratinocytes and plays an important role in the formation and/or maintenance of functional intercellular barriers. Acts as a regulator of intracellular Ca(2+) in synoviocytes. Plays an obligatory role as a molecular component in the nonselective cation channel activation induced by 4-alpha-phorbol 12,13-didecanoate and hypotonic stimulation in synoviocytes and also regulates production of IL-8. Together with PKD2, forms mechano- and thermosensitive channels in cilium. Negatively regulates expression of PPARGC1A, UCP1, oxidative metabolism and respiration in adipocytes. Regulates expression of chemokines and cytokines related to proinflammatory pathway in adipocytes. Together with AQP5, controls regulatory volume decrease in salivary epithelial cells. Required for normal development and maintenance of bone and cartilage. In its inactive state, may sequester DDX3X at the plasma membrane. When activated, the interaction between both proteins is affected and DDX3X relocalizes to the nucleus.; Non-selective calcium permeant cation channel involved in osmotic sensitivity and mechanosensitivity. Activation by exposure to hypotonicity within the physiological range exhibits an outward rectification. Also activated by phorbol esters. Has the same channel activity as isoform 1, and is activated by the same stimuli.; Lacks channel activity, due to impaired oligomerization and intracellular retention.; Lacks channel activity, due to impaired oligomerization and intracellular retention.; Lacks channel activity, due to impaired oligomerization and intracellular retention.; (Microbial infection) Facilitates hepatitis C virus (HCV) replication, possibly through its action on DDX3X.; (Microbial infection) Facilitates Dengue virus (DENV) replication, possibly through its action on DDX3X.; (Microbial infection) Facilitates Zika virus (ZIKV) replication, possibly through its action on DDX3X.
-
基因功能參考文獻:
- TRPV4 mediates Ca(2+) influx and nuclear accumulation of DDX3X in cells exposed to the Zika virus. Targeting of TRPV4 reduces infectivity of dengue, hepatitis C and Zika viruses. Our results highlight the role of TRPV4 in the regulation of DDX3X-dependent control of RNA metabolism and viral infectivity. PMID: 29899501
- Results suggest that transient receptor potential vanilloid 4 (TRPV4) accelerates glioma migration and invasion through the AKT/Rac1 signaling, and TRPV4 might be considered as a potential target for glioma therapy. PMID: 29928875
- study for the first time demonstrated an abnormal TRPV4-related mechanosensitive Ca(2+) signaling in Dilated cardiomyopathy induced-pluripotent stem cells-derived cardiomyocytes. PMID: 28754452
- There is expression of TRPV4 channels on the nerve fibers of human dental pulp. Findings suggest upregulation of TRPV4 expression under inflammatory conditions in the pulp. The upregulation of TRPV4 channels may be associated with the exaggerated response of dental pulp to innocuous mechanical, thermal and osmotic stimuli under inflammatory conditions. PMID: 29499561
- the antitumor effects caused by TRPV4 channel inhibition in hepatocellular carcinoma cell lines might be attributed to the suppression of epithelial-mesenchymal transition process and inactivation of phospho-ERK which induced subsequent cell apoptosis. PMID: 29635900
- Hypothermia-mediated increase in AQP4 surface abundance on human astrocytes, which was blocked using either calmodulin antagonist; TRPV4 antagonist or calcium chelation. A TRPV4 agonist mimicked the effect of hypothermia compared with untreated normothermic astrocytes. Hypothermia increased surface localization of AQP4 in human astrocytes likely through TRPV4 calcium channels and calmodulin activation. PMID: 28925524
- our study suggests a role for compound heterozygosity and loss-of-function as a potential novel disease mechanism for this group of disorders. Profound intellectual disability was also noted in both affected children, suggesting that TRPV4 may be necessary for normal brain development. PMID: 28898540
- Findings indicate that TRPV4 channels function as a critical component of mechano-sensitive, Ca2+-signaling machinery within the trabecular meshwork (TM), and that TRPV4-dependent cytoskeletal remodeling regulates TM stiffness and outflow. Thus, TRPV4 is a potential IOP sensor within the conventional outflow pathway. PMID: 27510430
- These results identify an essential role of TRPV4 in flow shear stress-induced early osteogenic differentiation of human mesenchymal stem cells. PMID: 28501773
- axonal colocalization of TRPV4 and TRPC6 was found in the digital Meissner corpuscles PMID: 27874267
- TRPV4 is essential for human retinal capillary endothelial cell migration and tube formation, and maybe a potential therapeutic target for retinal vascular diseases. PMID: 29433476
- TRPV4 is believed to be a mechanoreceptor in the bladder and is also involved in intercellular connectivity and structural integrity of the epithelium PMID: 27124500
- this study, demonstrates for the first time that calcium exerts an oncogenic action in the stomach through activation of CaSR and TRPV4 channels. Both CaSR and TRPV4 were involved in Ca2+-induced proliferation, migration, and invasion of gastric cancer cells through a Ca2+/AKT/beta-catenin relay, which occurred only in gastric cancer cells or normal cells overexpressing CaSR. PMID: 28951460
- TRPV4 involvement in RVD depends on the type of stimuli and/or degree of channel activation, leading to a maximum RVD response when Ca(2+) influx overcomes a threshold and activates further signaling pathways in cell volume regulation. PMID: 28098409
- Studies demonstrate that TRPV4 play a leading function in many fibrotic disease. Increasing evidence shows that TRPV4 modulated fibroblasts proliferation and differentiation to myofibroblasts. While in cystic fibrosis, the defective regulatory volume decrease might be caused by the absence TRPV4 and in pancreatic fibrosis, TRPV4 serves as a sensor responsive to inflammation, hypotonic saline and pain. [review] PMID: 29126921
- Arg594His substitution in TRPV4 causes SMD Kozlowski type. PMID: 28687525
- Data show that transient receptor potential vanilloid 4 (TRPV4)expression is enhanced in a subset of basal breast cancers. PMID: 28759041
- studies identified TRPV4 as a channel that contributes to both histamine- and chloroquine-induced itch and indicated that the function of TRPV4 in itch signaling involves TRPV1-mediated facilitation. PMID: 27436359
- the results of this study suggest that clinical evaluation of patients with musculoskeletal disorders similar to the peripheral neuropathies or skeletal dysplasias with scoliosis that have been ascribed to the TRPV4 spectrum could consider whether the phenotypes might result from somatic mosaicism in the target tissues affected in these phenotypes. PMID: 27530454
- A novel causative variant in the TRPV4 identified in a fetus with metatropic dysplasia in third trimester of pregnancy. PMID: 28414187
- reduced tissue osmolarity, likely following proteoglycan degradation, can increase TRPV4 signalling and enhance pro-inflammatory cytokine production. PMID: 27434269
- A novel TRPV4 mutation implicating TRPV4 and altered calcium homeostasis in the pathogenesis of osteonecrosis was identified while reinforcing the importance of TRPV4 in bone diseases and vascular endothelium. PMID: 27330106
- both TRPV2 and TRPV4 are involved in migration of human cardiac c-kit(+) progenitor cells. PMID: 26865051
- Data show that arylalkymine N-acetyltransferase (AANAT) levels and melatonin synthesis change after transient receptor potential channel 4 (TRPV4 channel) stimulation in ciliary body epithelial cells . PMID: 28368307
- TRPV4-induced calcium mobilization and inflammatory responses were enhanced in cystic fibrosis transmembrane conductance regulator-deficient cellular models. PMID: 27496898
- direct electrophysiological and pharmacological evidence for both TRPV4 and L-type Ca2+ conductances, as well as a tetraethylammonium (TEA)- and paxilline-sensitive K+ conductance in human pulmonary fibroblasts. PMID: 26851262
- We demonstrate that pharmacological activation or inhibition of TRPV4 regulates Ca(2+)-wave propagation from head to tail. Such findings may have wide application in male fertility-infertility, contraception and conservation of endangered species as well. PMID: 27003252
- These results confirm the function of TRPV4 in human cultured adipocytes and its regulation by insulin. PMID: 26381274
- Helicobacter pylori infection-dependent DNA methylation suppressed TRPV4 expression in human gastric epithelia, suggesting that TRPV4 methylation may be involved in Helicobacter pylori-associated dyspepsia. PMID: 27687509
- Phorbol myristate acetate increased TRPV4 expression in U937 and THP-1 cells. There was no significant difference in TRPV4 expression in the nLDL group but a significant reduction in TRPV4 expression was detected in the oxLDL group. PMID: 27706112
- TRPV4 rs6606743 SNP was found to significantly contribute to the development of osmotic airway hyperresponsiveness in response to the decrease in osmolarity under inspiration of distilled water aerosol was studies in 189 patients with uncontrolled bronchial asthma, prevalence of AG + GG genotype frequency in the group of patients with asthma with osmotic hyperresponsiveness PMID: 27599507
- Report of an Italian family with scapuloperoneal spinal muscular atrophy harboring the heterozygous missense mutation c.806G>A in the TRPV4 gene (p. R269H) and a literature review about scapuloperoneal spinal muscular atrophy PMID: 26948711
- TRPV4 channel activity modulates uterine contractility and might represent a therapeutic target to address preterm labor. PMID: 26702092
- In addition to the clear role TRPV4 plays in the growth plate, and its dysfunction leads to short-limbed and then short-trunked dwarfism, TRPV4 gain-of-function also leads to a state of increased bone turnover and osteopenia leading to fracture PMID: 26823048
- This study demonstrated that the overexpression and distribution patterns of TRPV4 may be linked with the intractable epilepsy caused by tuberous sclerosis complex. PMID: 26874068
- Overexpression and altered cellular distribution of TRPV4 observed in focal cortical dysplasia suggest that TRPV4 may potentially contribute to the epileptogenesis of focal cortical dysplasia PMID: 26842013
- Role of endothelial TRPV4 channels in vascular actions of the endocannabinoid, 2-arachidonoylglycerol PMID: 26294342
- the activation of myenteric TRPV4 and the subsequent production of NO by these neurons have the potential to become an important target for the pharmacological treatment of GI disorders with predominant hypermotility symptoms. PMID: 26330151
- these data strongly suggest endogenous TRPV4 channels as a mechanosensor, mediating cyclic stretch-induced realignment of hESC-CMs. PMID: 26259779
- Identify TRPV4 as novel regulator of neutrophil activation and suggest contributions of both parenchymal and neutrophilic TRPV4 in the pathophysiology of acute lung injury. PMID: 26222277
- TRPV4 regulates dynamics of trailing adhesions. PMID: 25559845
- A mutation in TRPV4 results in altered chondrocyte calcium signaling in severe metatropic dysplasia. PMID: 26249260
- Calcium sensitive TRPV4 translocation is associated with the regulation of endothelial response to mechanical stimulation. PMID: 26289129
- The inflammatory cytokine TNF-a can modulate the activity of the mechanosensitive ion channels TRPA1 and TRPV4 in odontoblasts via the p38 MAPK pathway but has differential effects on their expression. PMID: 26358221
- Interaction between the linker, pre-S1, and TRP domains determines folding, assembly, and trafficking of TRPV1 and TRPV4 channels. PMID: 26146187
- Neurography revealed a late-onset sensory neuropathy in the father, which was so far not described in TRPV4 neuropathies. PMID: 26110311
- P2Y1 couples to and activates TRPV4. PKC inhibitors prevented P2Y1 receptor activation of TRPV4. PMID: 26475857
- Mutations in the transient receptor potential vanilloid 4 gene have a broad phenotypic variability and disease severity and may share a similar pathogenic mechanism with Heat Shock Protein related neuropathies. PMID: 25900305
- Using multiple sequence alignments as source for evolutionary, bioinformatics and statistical analysis, we have analyzed the evolutionary profiles for TRPV1, TRPV2, TRPV3 and TRPV4 PMID: 25333484
- sensory proteins P2X3 and TRPV1 are in correlation with urothelial differentiation, while P2X5 and TRPV4 have unique expression patterns PMID: 24868547
顯示更多
收起更多
-
相關(guān)疾病:Brachyolmia 3 (BCYM3); Spondylometaphyseal dysplasia Kozlowski type (SMDK); Metatropic dysplasia (MTD); Neuronopathy, distal hereditary motor, 8 (HMN8); Charcot-Marie-Tooth disease 2C (CMT2C); Scapuloperoneal spinal muscular atrophy (SPSMA); Spondyloepiphyseal dysplasia Maroteaux type (SEDM); Parastremmatic dwarfism (PSTD); Digital arthropathy-brachydactyly, familial (FDAB); Avascular necrosis of the femoral head, primary 2 (ANFH2)
-
亞細胞定位:Cell membrane. Apical cell membrane; Multi-pass membrane protein. Cell junction, adherens junction. Cell projection, cilium.; [Isoform 1]: Cell membrane.; [Isoform 5]: Cell membrane.; [Isoform 2]: Endoplasmic reticulum.; [Isoform 4]: Endoplasmic reticulum.; [Isoform 6]: Endoplasmic reticulum.
-
蛋白家族:Transient receptor (TC 1.A.4) family, TrpV subfamily, TRPV4 sub-subfamily
-
組織特異性:Found in the synoviocytes from patients with (RA) and without (CTR) rheumatoid arthritis (at protein level).
-
數(shù)據(jù)庫鏈接:
Most popular with customers
-
-
YWHAB Recombinant Monoclonal Antibody
Applications: ELISA, WB, IHC, IF, FC
Species Reactivity: Human, Mouse, Rat
-
Phospho-YAP1 (S127) Recombinant Monoclonal Antibody
Applications: ELISA, WB, IHC
Species Reactivity: Human
-
-
-
-
-